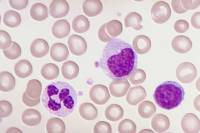
Sang et système circulatoire

L'histologie animale est la science qui étude les structures microscopiques des animaux et de l'Homme, et tout particulièrement celles des cellules et des tissus biologiques qui constituent les organes.
Dans cette première partie de l'histologie des animaux, les tissus sont regroupés par appareil (ou système). L'étude de certains types de tissus et cellules animales, telles que l'on peut les observer au microscope optique, est réalisée dans une rubrique spécifique.
- les cellules animales et certains tissus particuliers communs à différents organes (par ex. épithéliums, tissus sécréteurs, etc...)
- les divisions cellulaires ou mitoses
- le sang et le système circulatoire (coeur, artères, veines, capillaires sanguins, vaisseaux et capillaires lymphatiques)
- le système excréteur (rein, vessie, canaux urinaires, glandes sudoripares, glandes lacrymales,...)
- l'embryologie (des vertébrés en particulier)
- le système digestif (tube digestif, organes digestifs, organes annexes)
- le système immunitaire (organes lymphoïdes, cellules immunitaires,...)
- les protozoaires (vivants et colorés)